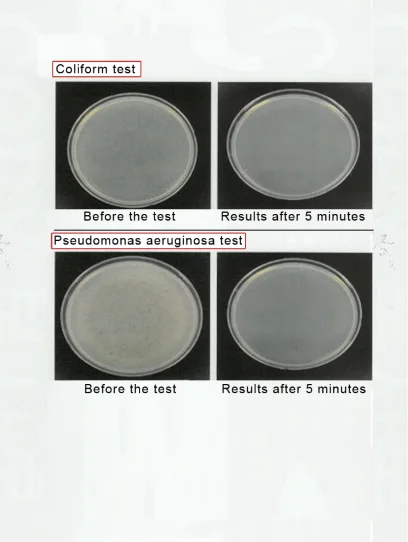
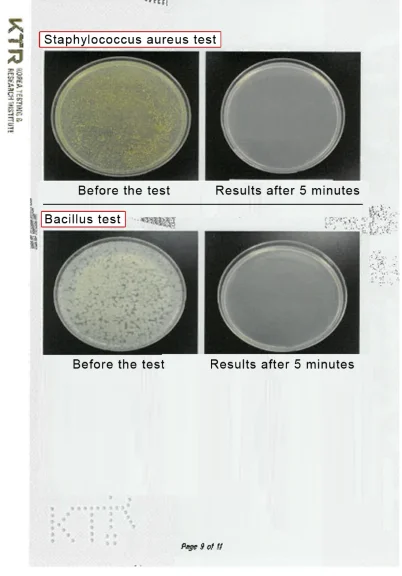

Share on (1700006464575):



item | value |
Use | Hand |
Form | Alcohol lotion |
NET WT | 80ml |
Feature | Moisturizing |
Supply Type | OEM/ODM |
Certification | MSDS |
Ingredient | Citric acid |
Age Group | Adults |
Place of Origin | South Korea |
Province | Ulsan |
Use | Hands |
Brand Name | Evergreenplus |
Product Name | Dr.cleanew |
Skin type | All-skin |
Type | Spray type |
Effect | Non-sticky |
Function | Sterilization/Odorless |
Volume | 100ml/500ml |
Main ingredient | Grain alcohol/Alkaline water |
Product Keywords | Multifuntional sterilization |

New products from manufacturers at wholesale prices